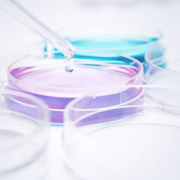
Ammonium

Jost Chemical Co.
About
Company description
High Purity Mineral Salts
For over 35 years, Jost Chemical has manufactured high-purity mineral salts for the nutritional, clinical nutritional, and pharmaceutical markets. All Jost products are
manufactured and tested at our 32,400-m2 FDA-registered manufacturing sites, including a new FSSC 22000-certified site in Kościan, Poland, which operates under bulk pharmaceutical cGMPs.
Jost Chemical is a leading supplier of high-purity mineral salts including, Calcium, Copper, Iron, Magnesium, Manganese and Zinc. Our wide selection of 250+ chemical salts includes citrates, gluconates, lactates, phosphates, malates, ascorbates, acetates, sulfates, oxides, carbonates, fumarates, and nitrates.
Product Highlights:
- Minerals for Infant Formula: For applications where purity is a must, we offer a new low chlorate Infant Pure product line as well as an Ultra Pure product line, Low Aluminum Calcium and Microencapsulated mineral salts.
- Chelates: Improve bioavailability with our 100% pure, fully reacted, high purity mineral chelates that are exceptionally low in heavy metals, including Magnesium Glycinate and Calcium Citrate Malate.
- Zinc for Immunity Products: Our line of high purity Zinc is ideal for your nutrition and immunity product applications including capsules, gelcaps, gummies, liquids, lozenges, tablets and powders.
Quick facts
| Sales markets | Africa; Asia; Australia; Central/South America; Eastern Europe; Middle East; North America; Western Europe |
|---|---|
| Primary business activity | Manufacturer: Ingredients / Additives |
| Affiliated categories: | Aluminium |Calcium |Calcium malate More |